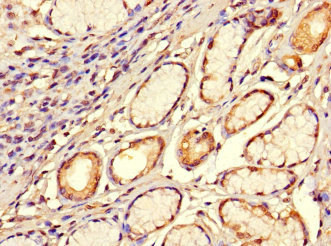
SMOC1 Antibody in Immunohistochemistry (Paraffin) (IHC (P))

Search








Please note: We are reviewing Western blot images included in the antibody testing data in our catalog, including those provided by third parties. Unless expressly labeled or annotated as “raw-unedited”, Western blot images included in the antibody testing data in our catalog may have been edited, optimized or otherwise adjusted for presentation.
产品信息
PA5-113408
种属反应
宿主/亚型
分类
类型
抗原
偶联物
形式
浓度
规格
纯化类型
保存液
内含物
保存条件
运输条件
RRID
靶标信息
Secreted modular calcium-binding protein 1 (SMOC1) is a gene located on chromosome 14q24.2, encoding a member of the SPARC (Secreted Protein, Acidic, and Rich in Cysteine) family of matricellular proteins. SMOC1 is characterized by its multiple domains that facilitate calcium binding and interaction with various components of the extracellular matrix. This protein plays a crucial role in modulating cell-matrix interactions and signaling pathways involved in cellular adhesion, migration, and differentiation. SMOC1 is expressed in multiple tissues, including the eyes, limbs, and the central nervous system, and is essential for developmental processes such as angiogenesis and tissue formation. Mutations in SMOC1 have been linked to ocular conditions like anterior segment dysgenesis and microphthalmia, reflecting its significance in eye development. Current studies focus on the protein's broader implications in developmental disorders and its potential as a therapeutic target in diseases associated with extracellular matrix dysregulation.
仅用于科研。不用于诊断过程。未经明确授权不得转售。
生物信息学
蛋白别名: Secreted modular calcium-binding protein 1; SMOC-1; SPARC-related modular calcium-binding protein 1
基因别名: SMOC1
Entrez Gene ID: (Human) 64093